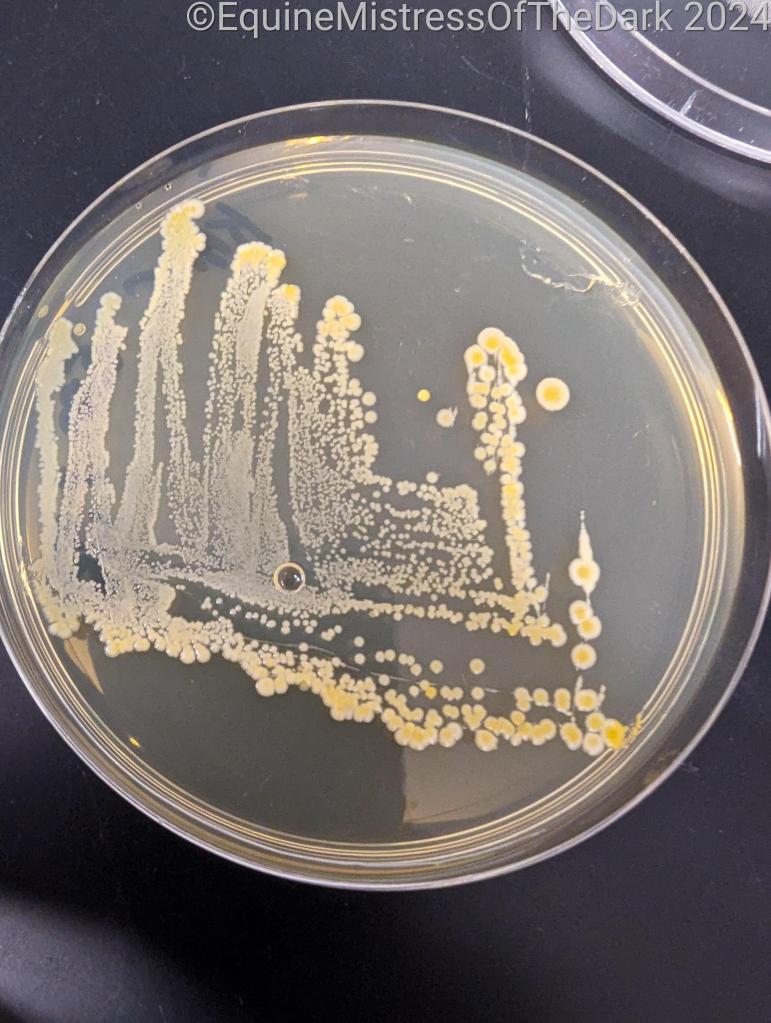

Hi and welcome to week 3!
I slept pretty well for me last night, I started waking up around 5 and tossing and turning, so I turned on Top Chef on Netflix and slept until about 930, when I decided to get up and get out of bed. I got out and had some cookies, because out of protein shakes, and turned on Top Chef again and started working on homework for microbiology class. It took me a little longer than the instructor said, but that’s okay. At least I got it done. I got a 9/10 on it, so I’m very happy, considering there were a few things that I was unsure about. I’m still not sure about some parts of it, so I’ll ask the instructor about them on Tuesday.
Fiks woke up while I was doing homework, so a hour to hour and a half later. He said he slept pretty well, tossing and turning like me after a point. I wonder if our tossing and turning was waking the other up. He made himself tea and jumped onto his computer, and I went and took a shower. I got dressed and talked to my parents, and then I set up a Discord for my microbiology class, so we could (me, I did it for me), get help from each other about the homework. After that I poked Fiks who was playing Baulders Gate III to see when he wanted to go get fish, we decided in like 30 minutes. Then his game auto saved, so he agreed to leave for fishes, and the hardware store for a new shower head and some rock salt for our water softener. We got a new extension cord for the fish tank going into the bedroom, and a new Pur water filter for the kitchen sink, because they don’t make filters for ours anymore.
While we were waiting in line, I saw an old friend, and I pointed him out to Fiks who went ‘He is tall’, I said I knew him and ran over and gave him a hug and we chatted for a few minutes and I introduced him to Fiks. It’s weird seeing someone that much taller than Fiks that he has to rock his head back to see them, I must admit it made me grin and giggle on the inside. We went and got our rock salt and then we went down the mountain to the pet store to get some fish.
We got to the store and parked, and the fish part of the store was packed, so it took a minute or two to get to the tank we wanted, and saw that they were being treated with medicine, again. They didn’t have everyone we needed either, so that’s okay. We looked at the Betta’s who are still very pretty. I of course liked the one that was hiding who was blue and gold, but we’re not quite ready for a Betta yet, still have to clean the small tank out. We checked out the other animals they had, rats, snakes, lizards, geckos.
We left the pet store empty handed, and Fiks took us for a drive along the coast and along where we used to live, so that was a nice treat. Fiks then drove to BevMo! and we wandered around a reason. We left with some tequila, beer, blood orange cider and Bailey’s minis. We then and got Fiks some gas for his car and came home. I moved the laundry while he poured the salt into the water softener, and then we came upstairs and I started doing some more homework and Fiks puttered about, hooking up the new shower head we got and then the extension cord in the bedroom. He’s currently playing BGIII and I’m going to wrap Poppa’s Birthday present.
After wrapping the present and waiting for Fiks to finish his fight, we made our way down the mountain towards 100. We got there and started help make dinner, which was Poppa’s request of enchilada’s and he made nachos for my Sister and Myself. There was also Spanish rice and beans. Dinner was good, even if my meat was super spicy (for me). Afterwards we moved to the living room and did presents, and Poppa got some After 8 mints, a book, a cool shirt, and the Lego Fiks and I got him. We then had the cake from the cheesecake factory and pie (for those of us who had room for both.) We hung out for a while, and then Fiks and I left to go to the grocery store and get home.


Once we got home and took out the recycling and garbage I sat down and watched my lecture videos, and some video’s on microbiology on YouTube that the teacher recommended. I put on some more Top Chef for a while and worked on my French with Duo, and then I went to bed.
I slept good for me last night, so that was nice. I didn’t want to wake up this morning, and since I didn’t have work, I didn’t. I got up around 830, grabbed a couple cookies for breakfast because I forgot to put a protein shake in the fridge. I turned on Top Chef and slept to that again for a while, before getting up and moving. I started a load of laundry, started doing some homework for both classes. I hope I did okay for my Women’s Studies class discussion assignment, and I started working on her paper last night. I redid some Microbiology stuff, super thankful that I was smart and took photos of the dishes with the different growths on them last class because I misread one part of the assignment.
I had some lunch and kept working on homework for a while, until I got a call from Fiks. We talked for a while before he had to go and I started working on this. Well, I moved laundry while I was on the phone with him. I’ve got to do my Women’s Studies reading still. C from work has been asking me to work her Monday in a couple of weeks, and I had something nagging in my brain that said I couldn’t do it, but I couldn’t remember why. I kept putting off committing to it, and then I remembered that I am working that day, just up front. She wasn’t happy with my answer and went to the manager (who I’m covering for) asking if we could switch, and she said no (thank you!).
I’ve been looking for something different to watch all day. Disney+ and Hulu aren’t accepting the passwords that Fiks gave me, so I’ll have him input them when he gets home. So I put on The Chilling Adventures of Sabrina until then.
I must have lost track of time, because Fiks was texting me that he was on his way home. I said I start on dinner, which was steak, potatoes and broccoli.

He jumped on the computer with his Monday night group, and I just hung out on the sofa talking with friends and enjoying Sabrina. When it was time I turned off the TV and went to bed and read Iron Flame for a while before putting on my audio book and falling asleep.
I slept really good for me last night, so that was nice. So good that I slept through 2 of my alarms to wake up and get my ass to school. I woke up with the third thankfully and got up and dressed, then I had my protein shake while I was watching Iron Chef before I packed up my stuff for school, fed the fish, headed down to the garage and headed to school.
Oh. My. God. Some people should just stick in the slow lane, going super slow in the fast lane, and then getting pissed when I got in the slow lane to pass and speeding up is just dumb. And it pissed me off because this stupid little Prius was doing exactly that the whole was up and down the mountain. I finally got around the stupid car, just in time for my exit, where I met more traffic. But I was able to maneuver my way through, even with CHP out and about. I got to school okay, so that’s good. I got out and headed to class, the teacher just opening the classroom as I approached, and it was nice and warm inside.
She moved us around on different tables, so I had to find my name tag and sit at that table, which was totally fine. Met some very nice people. Our assignment for the day was to collect some dirt somewhere on campus for some possible antibiotics and then spin/vibrate it down and collect samples from it. We were done with it really quickly.

Since we were done like an hour early, I went and got something to eat (a rice crispy treat), and then I sat at one of the tables doing the homework due on Thursday. I talked with a friend, figuring out where we could meet after I was done with class. We decided on a Pete’s Coffee over by his work. Then I went to lecture, but there was a class in it, so I couldn’t go in and sit down and get organized like I wanted to. Lecture went fine, just turned my brain into a pile of goop. At least she makes it relatable and interesting, unlike my last teacher, who is currently a tutor at the STEM Center. Needless to say I won’t be going to her there because she made me feel stupid for asking questions.
Anyway, after class I made my way to the truck and headed over to the Pete’s Coffee, where my friend was waiting. Took me a little bit to find it, but he was standing in front of it, so at least it was easy to spot. We went and got some tea/coffee (tea for me, coffee for him), and just hung out and chatted about different things. When the rain started to pick up I decided I needed to head home before there were any accidents, and he agreed. We said goodbye and then I hopped into my truck and headed home.
There were no accidents going my way home, thankfully. There was a bad one on the other side of the freeway though, just past the reservoir. There were CHP out and about on the mountain freeway, because it was raining, so I took it somewhat slow on my way home. I got home and texted my friend saying so, and then I went into the house and put on Sabrina and chilled/zoned/dozed to that for a while. Fiks said that he was on his way home and I asked him to pick up some food on the way home. He said sure and took my order, 2 quesadillas. Bad choice. I can eat one no problem, number 2 was a bit of a fight to get down.
I went and took a bath after dinner, reading A Game of Fate on my kindle for a good while. I came out and Fiks was on the computer with his friends. My brain was mush and the thought of doing more homework/classwork was brain melting. I watched Sabrina until it was bedtime. I kissed Fiks goodnight, took my meds, read Iron Flame and fell asleep.
I didn’t sleep the best last night, moving to the sofa at some point and turning on M*A*S*H. I woke up because I was cold, so I went back to bed and snuggled down next to Fiks. I did not want to wake up today, having good, if weird, dreams. Like I fully remember having a dream with Mike Ferrell from M*A*S*H being friends with my parents and then I was like “I KNEW IT!!”
Anyway, I just kept telling my alarm to snooze, so it did. I did get up and got my shake and drank that while watching Iron Chef, and then I fell asleep again. It took me a while to get up and going, running to make my lunch and then down to the truck to head to work. I went down the mountain after shooting my boss I was going to be a few minutes late. I was making good time until I wasn’t. There was a lot of traffic using my off ramp for work (rude!) which made me later than I wanted to be.
I parked my truck and went inside and went to work. It was just one of those morning for me. I stabbed myself really well with a clean needle while trying to do a blood draw on a dog. Like I look at it right now as I type and its black and blue and swollen. Normally when I stick myself it bleeds a little bit and then it stops. Not this time. I went through 2 paper towels before giving in and getting a band-aid. There were just little things to the morning that made it ‘one of those mornings’, nothing truly bad happened outside stabbing myself, but things just kept piling on.
After going to lunch I helped on the dental for a little while. I held the mouth open while A placed the sutures in the little dogs mouth from where she pulled teeth. G was doing the monitoring, S and M were puttering and L, like usual, was nowhere to be found when it came to cleaning. I got sent on my break after I had cleaned most of the dental machine, and L was still no where in sight when I came back. She showed up like 10 minutes after I got back, and I could tell G was pissed at her.
Appointments started rolling in and we started to room them. A left after a while, then it was just the 5 of us, then G left, so it was the 4 of us. L and I were to close down the clinic, thankfully we didn’t have any 440 appointments, so we were able to clean early. I came home and moved the laundry and took a shower, and then Fiks came home and said he wasn’t feeling well, so he went and lied down in bed and I worked on homework and ordered myself some Poke for dinner. Fiks came out after having a shower and warmed himself up some pancakes and then joined his friends on his computer. I started to do homework and worked on that until bedtime.
Didn’t sleep the best last night, I remember moving to the sofa and sleeping there for an hour or two before going back to bed. I was still mostly asleep when Fiks kissed me goodbye. I growled when my alarms went off later, sleeping in as much as I could before getting up and drinking my shake. I gathered my things for school then went and hopped into the truck.
The drive to school was fine. Almost saw 4 accidents happen right before my eyes, so that’s always a wonderful adrenaline dump while you’re driving. But I got to school in one piece, so that’s the important thing. I texted Fiks I got there okay and then I headed to class. The teacher had the room open, so it was nice and warm. She had shifted the name tags around again, so I was back at the first table but with different people. I gathered my things and cleaned down the table before sitting down.
Today we got to work with microscopes, so that was cool. I’m pretty comfortable with them at this point, so that took the edge off the pressure. We looked at some pre-made slides and then we started looking at live things on slides. We looked at water bears, pond water, amoeba, and something else that I can’t remember. We also got to look at our growth plates from last week, so that was cool. I mostly had one bacteria growing on my plate, but I did have a few spots of a second one growing, so I didn’t totally screw it up, just mostly.
After lab was done I went and got a cookie and a Twix because they were out of rice crispy treats, and then I went to lecture. Lecture was fine, I was just a little confused at its fast pace on the topic. We worked in pairs, working on cell structures in prokaryotic or eukaryotic cells. When I have a picture of them, I’m okay, when I have to draw and remember where everything else is, I have a harder time. Thankfully my partner was really good at cell structure and remembered a lot, but had me draw because apparently that wasn’t her strong suit.
After class I made my way home, and took a nap once I got there. I watched some Sabrina when I woke up and worked on classwork again. Fiks texted me he was on his way home, and I asked how he was feeling, and he said better, so I started working on dinner. Shrimp with broccoli and orzo. Turned out good.

I put on Iron Man 2 on and watched that for most of the night. Fiks stayed at his computer but was watching the TV over the top of his monitors.
When it was time I went to bed and read Iron Flame some more after meditating and fell asleep.
I had another night of crappy sleep. I moved to the sofa around one and turned on M*A*S*H and fell asleep until close to 5, then I went to crawl into bed and I swear that Fiks’ alarms started going off right when I got in and settled. I remember kissing him goodbye, and then I tossed and turned until my alarms went off. I got up and had my shake and got dressed and made my lunch and headed down the mountain to work.
I got there like 2 minutes late, changed into my work shoes and went inside. G, S, L and S turned and looked at me going ‘What are you doing here?’ ‘I start at 830.’ ‘No, you don’t’ ‘Well I did as of Wednesday’, then they all burst out laughing. The scheduled was changed on Thursday and not one of the 3 people on duty thought to text or to call me to tell me that my start time had changed. I was livid. I asked my manager when I saw her if she knew and she said no, and was pissed off as well. She apologized for it, so at least someone cared.
I punched in at 845, after learning that they had to let me punch in at 830 because I wasn’t informed of the schedule change. Then I started work. I kept rooming and helping the doctors, avoiding staying still too long. I kept cleaning surgery and surgery tools in between rooming. It was just a day for me.

One of the doctors noticed that I was off, and said something about it. I told her it was just work and school, not that the other girls were being mean to me. I got S’s phone number so she could help me with microbiology before she left. The last appointment of the day was a 95lbs Doberman pincher. Very sweet dog, just very wiggly when it came to taking his x-rays. When we were done we speed cleaned and then came home.
I beat Fiks home by 5 minutes, he stopped and got some stone fire pizza from down the street from where he works. It was really good, we finished it off. We watched YouTube for most of the night, at one point I got up and took a shower, because I was gross, and then came back out and read while sitting next to Fiks. We went to bed and read our books and fell asleep.
I slept better last night, but still not great. I had kicked my blankets off in the middle of the night, so I got cold and had to reorganize them and get them on the bed. I remember Fiks’ alarms going off and then him kissing me goodbye. I woke up with my alarms to a text saying that I didn’t work today, since there was only one doctor they only needed one receptionist, so I went back to sleep for a while after having my shake.
I got up and dressed and headed down the mountain to my parents house, swinging by to say hi. I got there when Poppa was making pancakes, so he offered me one and I said yes. I sat down and talked with Mom and then Poppa brought pancakes over; Mom got 2 but I got a Mickey Mouse one, so I’d say I got the better deal. I took the plates into the kitchen when we were done, Poppa working on his stack of pancakes, and then I took the tick out of Lumi’s eyebrow. He was a good boy for it, so that was nice. I put some Neosporin on it and then we tried to get Mom up and moving. She said she felt woozy and saw back down. Right when I was getting ready to leave, my Sister showed up, so that delayed me a few more minutes so I left when it was pissing down rain.
I went to the gas station and parked and then I couldn’t find my wallet, anywhere. I swear I had it yesterday, I prayed it was at home, so I left the gas station. I went to the pet shop to see if the GloFish were ready, it looked like a different batch than last week, but again, they were being quarantined. And they didn’t have any Betta fish. Not that I could buy any anyway. Afterwards I went and visited Fiks at work, and he was covering D’s lunch so he was watching the counter. I hung out with him for a while, then I made my way home.
I came home and had a sammich and then I put on Sabrina and fell asleep to that for a while. I woke up and realized I had homework due for Women’s Studies, so I did that. I did some reading for Microbiology and I was going to ask Fiks to bring home some paper, then I went and checked and we still had plenty. I put on Good Omens Season 2 after scrolling through Instagram for an hour, and then I started working on this. I tried to get the 49ers game, but we don’t have that channel/subscription so I only got a complimentary 5 minutes. As of right now we are loosing to Green Bay, but we still have a quarter to go, so hopefully that’ll turn around. Fiks got home around 7 and hopped into the shower.
We ended up winning, we learned that from the cheering of our neighbors. The minute before I was on the phone with Poppa and we were still loosing, so it was right down to the last second for us.
Alright, that’s it for this week
~Just Keep Swimming~



